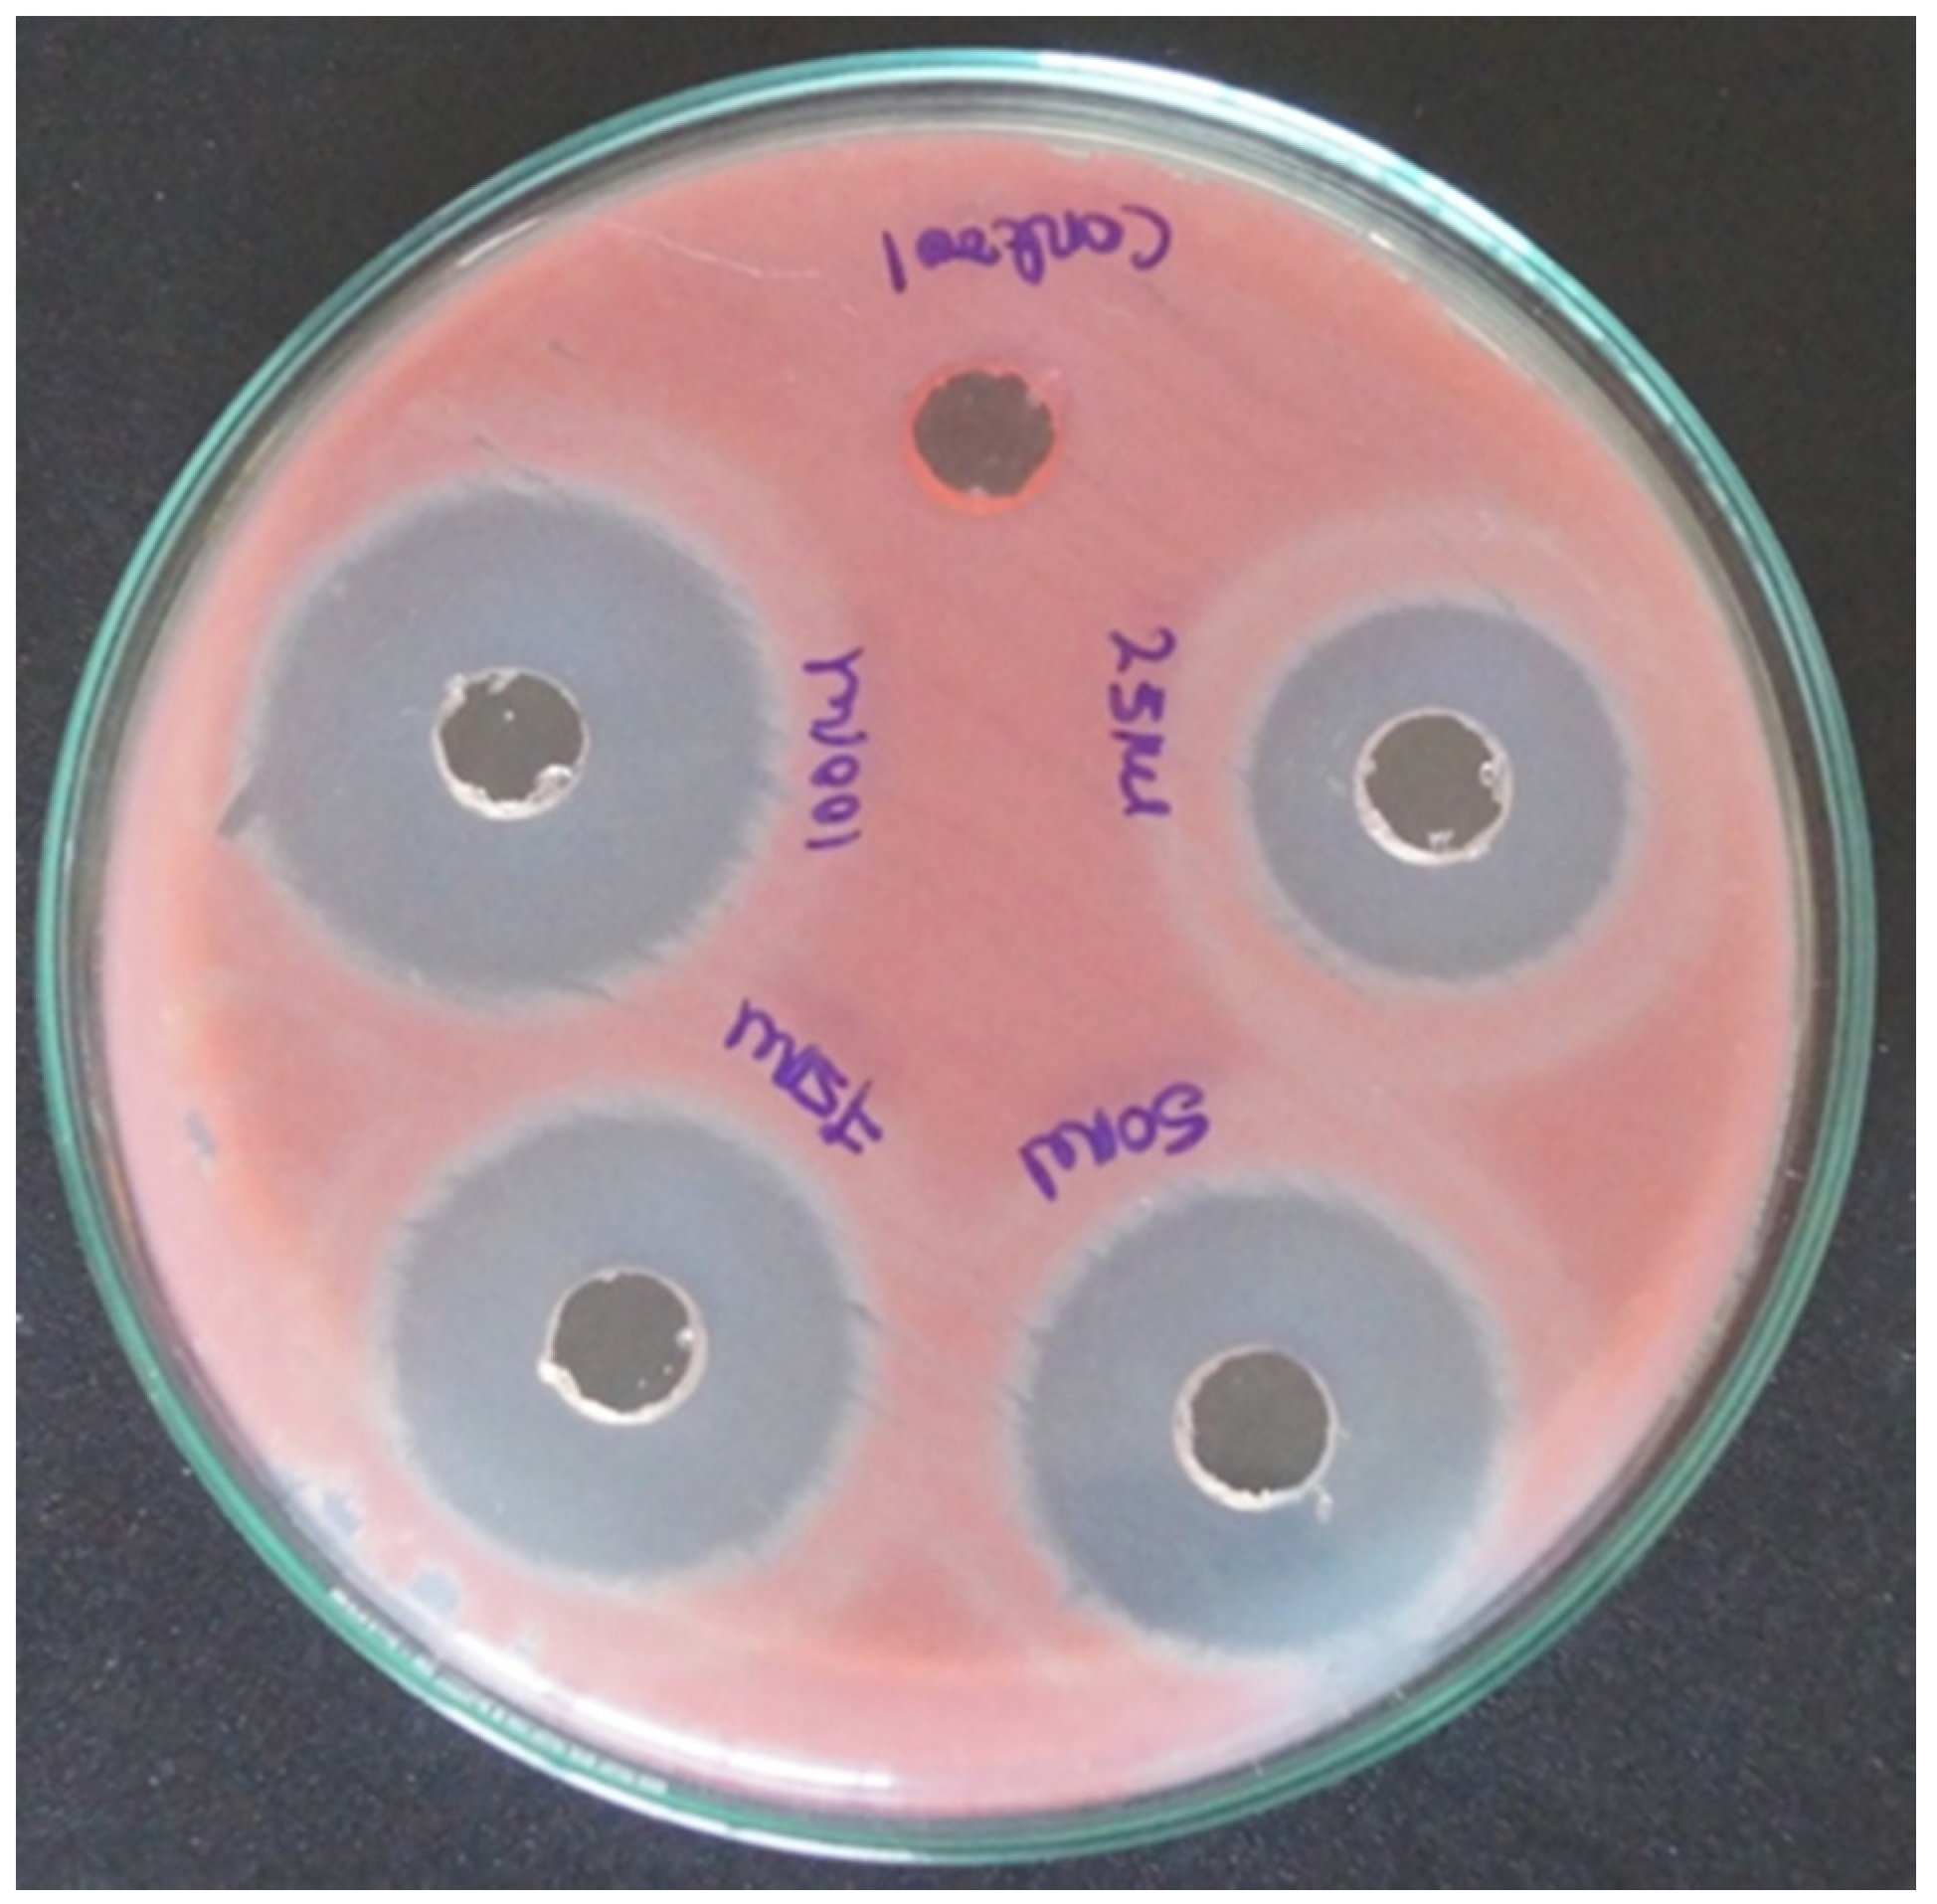
Coatings 10 00626 g005 Coatings 10 00626 g005

Leaf Extract of Dillenia indica as a Source of Selenium Nanoparticles with Larvicidal and Antimicrobial Potential toward Vector Mosquitoes and Pathogenic Microbes
Abstract
1. Introduction
2. Materials and Methods
2.1. Collection and Preparation of Leaves Broth
2.2. Green Synthesis of Selenium Nanoparticles
2.3. Characterization of Selenium Nanoparticles
2.4. Collection of Mosquito Eggs
2.5. Maintenance of Larvae
2.6. Maintenance of Pupae and Adult
2.7. Blood Feeding of Adult A. aegypti and C. quinquefasciatus
2.8. Larval Toxicity Test
2.9. Anti-Bacterial Activity
2.10. Histopathological Analysis
2.11. Statistical Analysis
3. Results
4. Discussion
5. Conclusions
Supplementary Materials
Author Contributions
Funding
Acknowledgments
Conflicts of Interest
References
- Talukdar, A.; Talukdar, N.; Deka, S.; Jyoti Sahariah, B. Dillenia Indica (Outenga) as anti-diabetic herb found in Assam: A review. Int. J. Pharm. Sci. Res. 2018, 3, 2482–2486. [Google Scholar]
- Janick, J.; Paull, R.E. The Encyclopedia of Fruit and Nuts, 1st ed.; CABI: London, UK, 2008. [Google Scholar]
- Dipal, G.; Priti, M. Dillenia indica Linn. and Dillenia pentagyna Roxb.: Pharmacognostic, Phytochemical and Therapeutic aspects. J. Appl. Pharm. Sci. 2013, 3, 134–142. [Google Scholar]
- Yazan, L.S.; Armania, N. Dillenia species: A review of the traditional uses, active constituents and pharmacological properties from pre-clinical studies. Pharm. Biol. 2014, 52, 890–897. [Google Scholar] [CrossRef] [PubMed]
- Abdille, M.H.; Singh, R.P.; Jayaprakasha, G.K.; Jena, B.S. Antioxidant activity of the extracts from Dillenia indica fruits. Food Chem. 2005, 90, 891–896. [Google Scholar] [CrossRef]
- Biswas, S.; Pandita, N. Phytochemical analysis and chromatographic evaluation of alcoholic extract of Dillenia indica linn Leaves. IJPSR 2015, 7, 2799–2812. [Google Scholar]
- Govindarajan, M.; Rajeswary, M.; Veerakumar, K.; Muthukumaran, U.; Hoti, S.L.; Benelli, G. Green synthesis and characterization of silver nanoparticles fabricated using Anisomeles indica: Mosquitocidal potential against malaria, dengue and Japanese encephalitis vectors. Exp. Parasitol. 2016, 161, 40–47. [Google Scholar] [CrossRef]
- Veerakumar, K.; Govindarajan, M. Adulticidal properties of synthesized silver nanoparticles using leaf extracts of Feronia elephantum (Rutaceae) against filariasis, malaria, and dengue vector mosquitoes. J. Ecobiotechnol. 2014, 113, 40–85. [Google Scholar] [CrossRef]
- Benelli, G. Plant-borne ovicides in the fight against mosquito vectors of medical and veterinary importance: A systematic review. Parasitol. Res. 2015, 114, 3201–3212. [Google Scholar] [CrossRef]
- Benelli, G.; Mehlhorn, H. Declining malaria, rising dengue and Zika virus: Insights for mosquito vector control. Parasitol. Res. 2016, 115, 1747–1754. [Google Scholar] [CrossRef]
- Muthukumaran, U.; Govindarajan, M.; Rajeswary, M. Synthesis and characterization of silver nanoparticles using Gmelinaasiatica leaf extract against filariasis, dengue, and malaria vector mosquitoes. Parasitol. Res. 2015, 114, 1817–1827. [Google Scholar] [CrossRef]
- Murugan, K.; Panneerselvam, C.; Subramaniam, J.; Madhiyazhagan, P.; Hwang, J.S.; Wang, L.; Dinesh, D.; Suresh, U.; Roni, M.; Higuchi, A.; et al. Eco-friendly drugs from the marine environment: Spongeweed-synthesized silver nanoparticles are highly effective on Plasmodium falciparum and its vector Anopheles stephensi, with little non-target effects on predatory copepods. Environ. Sci. Pollut. Res. 2016, 23, 16671–16685. [Google Scholar] [CrossRef] [PubMed]
- Kovendan, K.; Murugan, K.; Shanthakumar, S.P.; Vincent, S. Evaluation of larvicidal and pupicidal activity of Morinda citrifolia L. (Noni) (Family: Rubiaceae) against three mosquito vectors. Asian Pac. J. Trop. Med. 2012, 2, S362–S369. [Google Scholar] [CrossRef]
- Pavela, R.; Benelli, G. Ethnobotanical knowledge on botanical repellents employed in the African region against mosquito vectors a review. Plant Prot. Sci. 2016, 167, 103–108. [Google Scholar] [CrossRef] [PubMed]
- Murugan, K.; Sanoopa, C.P.; Madhiyazhagan, P.; Dinesh, D.; Subramaniam, J.; Panneerselvam, C.; Roni, M.; Suresh, U.; Nicolettib, M.; Alarfajc, A.A.; et al. Rapid biosynthesis of silver nanoparticles using Crotalaria verrucosa leaves against the dengue vector Aedes aegypti: What happens around. An analysis of dragonfly predatory behaviour after exposure at ultra-low doses. Parasitol Res. 2015, 114, 2243–2253. [Google Scholar] [CrossRef] [PubMed]
- Alyahya, I.A.; Almohsen, H.A.; AlSaleem, I.A.; Al-Hamid, M.M.; Arafah, A.M.; Al Turki, Y.A. Assessment of knowledge, attitude, and practice about first aid among male school teachers and administrators in Riyadh, Saudi Arabia. J. Fam. Med. Prim. Care 2019, 8, 684–688. [Google Scholar] [CrossRef]
- World Health Organization. Dengue and Severe Dengue Fact Sheet. 2015. Available online: www.elsevier.com/locate/parepi (accessed on 26 February 2020).
- Sutthanont, N.; Siriluck, A.; Surang, N. Larvicidal Activity of Synthesized Silver Nanoparticles from Curcuma zedoaria Essential Oil against Culex Quinquefasciatus. Insects 2019, 10, 27. [Google Scholar] [CrossRef]
- Subra, R.; Service, M.W.; Mosha, F.W. The effect of domestic detergents on the population dynamics of the immature stages of two competitor mosquitoes, Culex cinereus Theobald and Culex quinquefasciatus Say (Diptera, Culicidae) in Kenya. Acta Trop. 1984, 41, 69–75. [Google Scholar]
- Ajayi, M.B.; Adeleke, M.A.; Idowu, E.T.; Awolola, T.S. Surveillance of mosquitoes vectors in Ajumoni Estate Ogun State, Nigeria. Ann. Biol. Res. 2010, 1, 16–19. [Google Scholar]
- Levin, N.; Zahavi, J. Predictive modeling using segmentation. J. Interact. Mark. 2001, 15, 2–22. [Google Scholar] [CrossRef]
- Rizzello, L.; Pompa, P.P. Nanosilver-based antibacterial drugs and devices: Mechanisms, methodological drawbacks, and guidelines. Chem. Soc. Rev. 2014, 43, 1501–1518. [Google Scholar] [CrossRef]
- Lin, P.L.; Oram, R.J.; Lauderdale, D.S. Requirement of NAD and SIR2 for life-span extension by calorie restriction in Saccharomyces cerevisiae. Science 2000, 289, 2126–2128. [Google Scholar] [CrossRef] [PubMed]
- Ghalehnoo, Z.R. Diseases caused by Staphylococcus Aureus. Int. J. Med. Health Res. 2018, 4, 65–67. [Google Scholar]
- Okuda, T.; Endo, N.; Osada, Y.; ZenYoji, H. Outbreak of nosocomial urinary tract infections caused by Serratia marcescens. Enzyme 1984, 20, 691–695. [Google Scholar] [CrossRef]
- Buckle, J. Infection, Clinical Aromatherapy, 3rd ed.; Elsevier: Amsterdam, The Netherlands, 2015; Volume 7, pp. 130–167. [Google Scholar]
- Santhosh, S.B.; Ragavendran, C.; Natarajan, D. Spectral and HRTEM analyses of Annona muricata leaf extract mediated silver nanoparticles and its Larvicidal efficacy against three mosquito vectors Anopheles stephensi, Culex quinquefasciatus, and Aedes aegypti. J. Photochem. Photobiol. 2015, 153, 184–190. [Google Scholar] [CrossRef] [PubMed]
- Veerakumar, K.; Govindarajan, M.; Rajeswary, M. Green synthesis of silver nanoparticles using Sidaacuta (Malvaceae) leaf extract against Culex quinquefasciatus, Anopheles stephensi, and Aedes aegypti (Diptera: Culicidae). Parasitol. Res. 2013, 112, 4073–4085. [Google Scholar] [CrossRef] [PubMed]
- Nathiya, S.; Santhi, N.; Kalaiselvi, S. A comparative study on ontogenic expression of antioxidants and secondary metabolites in Withania somnifera. Int. J. Curr. Sci. 2012, 3, 210–215. [Google Scholar]
- Singh, S.; Singh, B.K.; Yadav, S.M.; Gupta, A.K. Applications of Nanotechnology in Agricultural and their Role in Disease Management. Res. J. Nanosci. Nanotechnol. 2015, 5, 1–5. [Google Scholar] [CrossRef]
- Sosa, I.O.; Noguez, C.; Barrera, R.G. Optical properties of metal nanoparticles with arbitrary shapes. J. Phys. Chem. B 2003, 107, 6269–6975. [Google Scholar] [CrossRef]
- Sunanda, K.; Kikuchi, Y.; Hashimoto, K.; Fujishima, A. Bactericidal and detoxification effects of TiO2 thin film photocatalysts. Environ. Sci. Technol. 1998, 32, 726–728. [Google Scholar] [CrossRef]
- Taylor, P.L.; Ussher, A.L.; Burrell, R.E. Impact of heat on nanocrystalline silver dressings. Part I: Chemical and biological properties. Biomaterials 2005, 26, 7221–7229. [Google Scholar] [CrossRef]
- Ingle, A.; Gade, A.; Pierrat, S.; Sonnichsen, C.; Rai, M. Mycosynthesis of silver nanoparticles using the fungus Fusarium acuminatum and its activity against some human pathogenic bacteria. Curr. Nanosci. 2008, 4, 141–144. [Google Scholar] [CrossRef]
- Duran, N.; Marcato, P.D.; Alves, O.L.; Souza, G. Mechanistic aspects of biosynthesis of silver nanoparticles by several Fusariumoxy sporum strains. J. Nanotechnol. 2005, 3, 1–7. [Google Scholar]
- Morejon, B.; Pilaquinga, F.; Domenech, F.; Ganchala, D.; Debut, A.; Neira, M. Larvicidal Activity of Silver Nanoparticles Synthesized Using Extracts of Ambrosia arborescens (Asteraceae) to Control Aedes aegypti L. (Diptera: Culicidae). J. Nanotechnol. 2018, 2018, 6917938. [Google Scholar] [CrossRef]
- Barik, T.K.; Kamaraju, R. Silica nanoparticle: A potential new insecticide for mosquito vector control. Parasitol. Res. 2012, 111, 1075–1083. [Google Scholar] [CrossRef] [PubMed]
- Deepak, P.; Amutha, V.; Birundha, R.; Sowmiya, R.; Kamaraj, C.; Balasubramanian, V.; Balasubramani, G.; Aiswarya, D.; Arul, D.; Perumal, P. Facile green synthesis of nanoparticles from brown seaweed Sargassum wightii and its biological application potential. Adv. Nat. Sci. Nanosci. Nanotechnol. 2018, 9, 035019. [Google Scholar] [CrossRef]
- Murugan, K.; Dinesh, D.; Nataraj, D.; Subramaniam, J.; Amuthavalli, P.; Madhavan, J.; Rajasekar, A.; Rajan, M.; Palani Thiruppathi, K.; Suresh, K.; et al. Iron and iron oxide nanoparticles are highly toxic to Culex quinquefasciatus with little non-target effects on larvivorous fishes. Environ. Sci. Pollut. Res. 2017. [Google Scholar] [CrossRef] [PubMed]
- Benelli, G.; Pavela, R.; Canale, A.; Cianfaglione, K.; Ciaschetti, G.; Conti, F.; Nicoletti, M.; Senthil-Nathan, S.; Mehlhorn, H.; Maggi, F. Acute Larvicidal Toxicity of Five Essential Oils (Pinus nigra, Hyssopus officinalis, Satureja montana, Aloysia citrodora and Pelargonium graveolens) Against the Filariasis Vector Culex Quinquefasciatus: Synergistic and Antagonistic Effects. Parasitol. Int. 2017, 66, 166–171. [Google Scholar] [CrossRef]
- Bai, X.; Mou, C.; Xu, L.; Wang, S.; Pu, S.; Zeng, X. Passively Q-switched erbium-doped fiber laser using Fe3O4-nanoparticle saturable absorber. Jpn. Soc. Appl. Phys. 2016, 9, 042701. [Google Scholar] [CrossRef]
- Rayman, M.; Thompson, A.; Warren-Perry, M.; Galassini, R.; Catterick, J.; Hall, E.; Lawrence, D.; Bliss, J. Impact of selenium on mood and quality of life: A randomized, controlled trial. Biol. Psychiatry 2006, 59, 147–154. [Google Scholar] [CrossRef]
- Schomburg, L. Dietary selenium and human health. Nutrients 2017, 9, 22. [Google Scholar] [CrossRef]
- Bozena, H.; Marta, K.; Sylvie, S.; Carlos, F.; Branislav, R.N.; Qiuming, P.; Mojmir, B.; Magdalena, M.; Radka, O.; Jarmila, Z.; et al. Nano-selenium and its nanomedicine applications: A critical review. Int. J. Nanomed. 2018, 13, 2107–2128. [Google Scholar]
- Ajitha, B.; Reddy, Y.A.; Reddy, P.S. Green synthesis and characterization of silver nanoparticles using Lantana camara leaf extract. Mater. Sci. Eng. C 2015, 49, 373–381. [Google Scholar] [CrossRef] [PubMed]
- Guo, M.; Li, W.; Yang, F.; Liu, H. Controllable biosynthesis of gold nanoparticles from a Eucommia ulmoides bark aqueous extract. Spectrochim. Acta Part A Mol. Biomol. Spectrosc. 2015, 142, 73–79. [Google Scholar] [CrossRef] [PubMed]
- Dhanjal, S.; Singh, C. Aerobic biogenesis of selenium nanospheres by Bacillus cereus isolated from coalmine soil. Microb. Cell Factories 2010, 52, 1–11. [Google Scholar] [CrossRef] [PubMed]
- Venkatesan, S.; Sujatha, K. Characterization of Barnyard Millet Cultivars using Seed Image Analysis. Seed Res. J. 2018, 45, 1–3. [Google Scholar]
- Gunti, M.; Ramachandran, D.; Bharat, P. Design and Preparation of Guar Gum Nano Particles Based on Emulsification Technique. Int. J. Chemtech. Res. 2019, 12, 189–193. [Google Scholar]
- Ramamurthy, C.H.; Sampath, K.S.; Arunkumar, P.; Suresh Kumar, M.; Sujatha, V.; Premkumar, K.; Thirunavukkarasu, C. Green Synthesis and Characterization of Selenium Nanoparticles and Its Augmented Cytotoxicity with Doxorubicin on Cancer Cells. Bioprocess Biosyst. Eng. 2013, 36, 1131–1139. [Google Scholar] [CrossRef]
- Cui, D.; Liang, T.; Sun, L.; Meng, L.; Yang, C.; Wang, L.; Liang, T.; Li, Q. Green synthesis of selenium nanoparticles with extract of hawthorn fruit induced HepG2 cells apoptosis. Pharm. Biol. 2018, 56, 528–534. [Google Scholar] [CrossRef]
- Fardsadegh, B.; Jafarizadeh-Malmiri, H. Aloe vera leaf extract mediated green synthesis of selenium nanoparticles and assessment of their In vitro antimicrobial activity against spoilage fungi and pathogenic bacteria strains. Green Process. Synth. 2019, 8, 399–407. [Google Scholar] [CrossRef]
- Sharma, G.; Sharma, A.R.; Bhavesh, R.; Jongbong, P.; Ganbold, B.; Ju-Suk, N.; Sang-Soo, L. Biomolecule-Mediated Synthesis of Selenium Nanoparticles using Dried Vitis vinifera (Raisin) Extract. Molecules 2014, 19, 2761–2770. [Google Scholar] [CrossRef]
- Tan, D.J.; Dvinge, H.; Christoforou, A.; Bertone, P.; Martinez Arias, A.; Lilley, K.S. Supporting Information: Table S5. Localizations of proteins predicted by LOPIT. J. Proteome Res. 2009, 8, 2667–2678. [Google Scholar] [CrossRef]
- Azmi, W.; Sani, R.K.; Banerjee, U.C. Biodegradation of triphenylmethane dyes. Enzym. Microb. Technol. 1998, 22, 185–191. [Google Scholar] [CrossRef]
- Abbott, W.S. A method of computing the effectiveness of an insecticide. J. Econ. Entomol 1925, 18, 265–267. [Google Scholar] [CrossRef]
- Kalagatur, N.K.; Mudili, V.; Siddaiah, C.; Gupta, V.K.; Natarajan, G.; Sreepathi, M.H.; Vardhan, B.H.; Putcha, V.L.R. Antagonistic activity of Ocimum sanctum L. essential oil on growth and zearalen one production by Fusarium graminearum in maize grains. Front. Microbiol. 2015, 6, 892. [Google Scholar] [CrossRef]
- Fallatah, S.A.; Khater, E.I. Potential of medicinal plants in mosquito control. J. Egypt Soc. Parasitol. 2010, 40, 1–26. [Google Scholar]
- Suganya, G.; Karthi, S.; Shivakumar, M.S. Larvicidal potential of silver nanoparticles synthesized from Leucas aspera leaf extracts against dengue vector Aedes Aegypti. Parasitol. Res. 2014, 113, 875–880. [Google Scholar] [CrossRef] [PubMed]
- Gilbert, P.; Allison, D.G.; McBain, A.J. Biofilms in vitro and in vivo: Do singular mechanisms imply cross-resistance. Symp. Ser. Soc. Appl. Microbiol. 2002, 92, 98S–110S. [Google Scholar] [CrossRef]
- Trinh, T.D.; Zasowski, E.J.; Claeys, K.C.; Casapao, A.M.; Compton, M.; Lagnf, A. Role of vancomycin minimum inhibitory concentrations by modifed population analysis profle method and clinical outcomes in high inoculum methicillin-resistant Staphylococcus Aureus Infections. Infect. Dis. Ther. 2018, 7, 161–169. [Google Scholar] [CrossRef]
- Roni, M.; Murugan, K.; Panneerselvam, C.; Subramaniam, J.; Nicoletti, M.; Madhiyazhagan, P.; Dinesh, D.; Udaiyan, S.U.; Hanem, F.; Wei, H.; et al. Characterization and biotoxicity of Hypnea musciformis synthesized silver nanoparticles as potential eco-friendly control tool against Aedes aegypti and Plutella Xylostella. Ecotoxicol. Environ. Saf. 2015, 121, 31–38. [Google Scholar] [CrossRef]
- Wang, T.; Yang, L.; Zhang, B.; Liu, J. Extracellular biosynthesis and transformation of selenium nanoparticles and application in H2O2 biosensor. Colloid Surf. B 2010, 80, 94–102. [Google Scholar] [CrossRef]
- Malhotra, S.; Jha, N.; Desai, K.A. Superficial synthesis of selenium nanospheres using wet chemical approach. Int. J. Nanotechnol. 2014, 3, 7–14. [Google Scholar]
- Prasad, R.; Kumar, V.; Prasad, K.S. Nanotechnology in sustainable agriculture: Present concerns and future aspects. Afr. J. Biotechnol. 2014, 13, 705–713. [Google Scholar]
- Ezhuthupurakkal, P.B.; Polaki, L.R.; Suyavaran, A.; Subastri, A.; Sujatha, V.; Thirunavukkarasu, C. Selenium nanoparticles synthesized in aqueous extract of Allium sativum perturbs the structural integrity of Calf thymus DNA through intercalation and groove binding. Mater. Sci. Eng. C 2017, 74, 597–608. [Google Scholar] [CrossRef] [PubMed]
- Singh, N.; Saha, P.; Rajkumar, K.; Abraham, J. Biosynthesis of silver and selenium nanoparticles by Bacillus sp. JAPSK2 and evaluation of antimicrobial activity. Der Pharm. Lett. 2014, 6, 175–181. [Google Scholar]
- Wang, S.; McGuirk, M.; Andrea, D.; AquinoJarad, C.; MasonChad, A.; Mirkin, A. Metal–Organic Framework Nanoparticles. Adv. Mater. 2018. [Google Scholar] [CrossRef] [PubMed]
- Salem, S.S.; Fouda, M.M.G.; Fouda, A. Antibacterial, Cytotoxicity and Larvicidal Activity of Green Synthesized Selenium Nanoparticles Using Penicillium corylophilum. J. Clust. Sci. 2020. [Google Scholar] [CrossRef]
- Sowndarya, P.; Ramkumar, G.; Shivakumar, M.S. Green synthesis of selenium nanoparticles conjugated Clausenadentata plant leaf extract and their insecticidal potential against mosquito vectors. Artif. Cells 2016, 45, 1–6. [Google Scholar] [CrossRef]
- Sarkar, J.; Dey, P.; Saha, S.; Acharya, K. Mycosynthesis of selenium nanoparticles. Micro Nano Lett. 2011, 6, 599–602. [Google Scholar] [CrossRef]
- Alam, H.; Khatoon, N.; Raza, M.; Ghosh, P.C.; Sardar, M. Synthesis and characterization of nano selenium using plant biomolecules and their potential applications. BioNanoScience 2018, 9, 96–104. [Google Scholar] [CrossRef]
- Zhang, J.; Wang, W.; Yongping, B.; Zhang, L. Nano red elemental selenium has no size effect in the induction of seleno-enzymes in both cultured cells and mice. Life Sci. 2004, 75, 237–244. [Google Scholar] [CrossRef]
- Soni, N.; Prakash, S. Green Nanoparticles for Mosquito Control. Sci. World J. 2014, 2014, 496362. [Google Scholar] [CrossRef] [PubMed]
- Benelli, G.; Maggi, F.; Pavela, R.; Murugan, K.; Govindarajan, M.; Vaseeharan, B.; Petrelli, R.; Cappellacci, L.; Kumar, S.; Hofer, A.; et al. Mosquito control with green nanopesticides: Towards the One Health approach? A review of non-target effects. Environ. Sci. Pollut. 2017. [Google Scholar] [CrossRef] [PubMed]
- Tran, P.A.; Brien Simpson, N.; Reynolds, E.C.; Pantarat, N.; Biswas, D.P.; Connor, A.J. Low cytotoxic trace element selenium nanoparticles and their differential antimicrobial properties against S. aureus and E. coli. Nanotechnology 2015, 27, 045101. [Google Scholar] [CrossRef] [PubMed]
- Tran, P.A.; Webster, T.J. Selenium nanoparticles inhibit Staphylococcus aureus growth. Int. J. Nanomed. 2011, 6, 1553–1558. [Google Scholar] [CrossRef]
- Seil, J.T.; Webster, T.J. Antimicrobial applications of nanotechnology: Methods and literature. Int. J. Nanomed. 2012, 7, 27–67. [Google Scholar]
- Sonkusre, P.; Nanduri, R.; Gupta, P.; Cameotra, S.S. Improved extraction of intracellular biogenic selenium nanoparticles and their specificity for cancer chemoprevention. Sci. Signal. 2014, 7, 333–366. [Google Scholar] [CrossRef]
- Nakayama, H.; Kurokawa, K.; Lee, B.L. Lipoproteins in bacteria: Structures and biosynthetic pathways. FEBS J. 2012, 279, 4247–4268. [Google Scholar] [CrossRef]
- Rehman, M.A.; Ferraris, S.; Goldmann, W.H.; Perero, S.; Bastan, F.E.; Nawaz, Q.; Confiengo, G.G.D.; Ferraris, M.; Boccaccini, A.R. Antibacterial and Bioactive Coatings Based on Radio Frequency Co-Sputtering of Silver Nanocluster-Silica Coatings on PEEK/Bioactive Glass Layers Obtained by Electrophoretic Deposition. J. Biosoc. Sci. 2017, 9, 32489–32497. [Google Scholar] [CrossRef]
- Seuss, S.; Heinloth, M.; Boccaccini, A.R. Development of bioactive composite coatings based on combination of PEEK, bioactive glass and Ag nanoparticles with antibacterial properties. Surf. Coat. Technol. 2016, 301, 100–105. [Google Scholar] [CrossRef]
- Garcia, C.P.; Burchardt, A.D.; Carvalho, R.N.; Gilliland, D.; Antonio, D.C.; Rossi, F.; Lettieri, T. Detection of Silver Nanoparticles inside Marine Diatom Thalassiosira pseudonana by Electron Microscopy and Focused Ion Beam. PLoS ONE 2014, 9, e96078. [Google Scholar]
- Matsumura, Y.; Yoshikata, K.; Kunisaki, S.; Tsuchido, T. Mode of bactericidal action of silver zeolite and its comparison with that of silver nitrate. Appl. Environ. Microbiol. 2003, 69, 4278–4281. [Google Scholar] [CrossRef] [PubMed]

| S. No. | Larval Stages | Larvae Introduced | Mortality/Concentration (mg/L) | LC50 | LC90 | X2 | |||
|---|---|---|---|---|---|---|---|---|---|
| Control | 10 ppm/uL | 50 ppm/uL | 100 ppm/uL | ||||||
| 1. | I instar | 100 | 0 ± 0 | 76.00 ± 2.30 | 80.00 ± 0.00 | 90.00 ± 0.00 | 0.39 | 199.58 | 1.98 * |
| 2. | II instar | 100 | 0 ± 0 | 62.66 ± 14.42 | 78.66 ± 2.30 | 80.00 ± 2.30 | 2.42 | 507.17 | 0.38 * |
| 3. | III instar | 100 | 0 ± 0 | 53.33 ± 6.11 | 70.66 ± 2.30 | 77.33 ± 2.30 | 7.50 | 637.08 | 0.10 * |
| 4. | IV instar | 100 | 0 ± 0 | 44.00 ± 4.00 | 58.66 ± 2.30 | 68.00 ± 4.00 | 18.63 | 2517.46 | 0.15 * |
| 5. | Pupa | 100 | 0 ± 0 | 40.00 ± 4.00 | 52.00 ± 4.00 | 62.66 ± 2.30 | 31.25 | 6644.22 | 0.39 * |
| S. No. | Larval Stages | Larvae Introduced | Mortality/Concentration (Mg/L) | LC50 | LC90 | X2 | |||
|---|---|---|---|---|---|---|---|---|---|
| Control | 10 ppm/uL | 50 ppm/uL | 100 ppm/uL | ||||||
| 1. | I instar | 100 | 0 ± 0 | 89.33 ± 2.30 | 97.33 ± 2.30 | 100.00 ± 0.00 | 1.11 | 11.09 | 1.19 * |
| 2. | II instar | 100 | 0 ± 0 | 80.00 ± 0.00 | 93.33 ± 2.30 | 100.00 ± 0.00 | 2.50 | 22.64 | 3.40 * |
| 3. | III instar | 100 | 0 ± 0 | 73.33 ± 2.30 | 82.66 ± 2.30 | 100.00 ± 0.00 | 2.87 | 46.82 | 12.87 * |
| 4. | IV instar | 100 | 0 ± 0 | 74.66 ± 2.30 | 88.00 ± 4.00 | 98.66 ± 2.30 | 3.25 | 38.21 | 4.27 * |
| 5. | Pupa | 100 | 0 ± 0 | 46.66 ± 2.30 | 62.66 ± 2.30 | 89.33 ± 2.30 | 14.09 | 203.26 | 8.76 * |
© 2020 by the authors. Licensee MDPI, Basel, Switzerland. This article is an open access article distributed under the terms and conditions of the Creative Commons Attribution (CC BY) license (http://creativecommons.org/licenses/by/4.0/).
Share and Cite
Krishnan, M.; Ranganathan, K.; Maadhu, P.; Thangavelu, P.; Kundan, S.; Arjunan, N. Leaf Extract of Dillenia indica as a Source of Selenium Nanoparticles with Larvicidal and Antimicrobial Potential toward Vector Mosquitoes and Pathogenic Microbes. Coatings 2020, 10, 626. https://doi.org/10.3390/coatings10070626
Krishnan M, Ranganathan K, Maadhu P, Thangavelu P, Kundan S, Arjunan N. Leaf Extract of Dillenia indica as a Source of Selenium Nanoparticles with Larvicidal and Antimicrobial Potential toward Vector Mosquitoes and Pathogenic Microbes. Coatings. 2020; 10(7):626. https://doi.org/10.3390/coatings10070626
Chicago/Turabian StyleKrishnan, Meenambigai, Kokila Ranganathan, Premkumar Maadhu, Pazhanivel Thangavelu, Sivashanmugan Kundan, and Nareshkumar Arjunan. 2020. "Leaf Extract of Dillenia indica as a Source of Selenium Nanoparticles with Larvicidal and Antimicrobial Potential toward Vector Mosquitoes and Pathogenic Microbes" Coatings 10, no. 7: 626. https://doi.org/10.3390/coatings10070626
APA StyleKrishnan, M., Ranganathan, K., Maadhu, P., Thangavelu, P., Kundan, S., & Arjunan, N. (2020). Leaf Extract of Dillenia indica as a Source of Selenium Nanoparticles with Larvicidal and Antimicrobial Potential toward Vector Mosquitoes and Pathogenic Microbes. Coatings, 10(7), 626. https://doi.org/10.3390/coatings10070626





